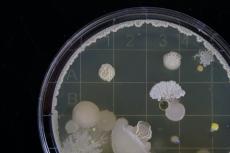
Schimmelpilz mit Sporen (unter dem Mikroskop)

Wie kommt es, dass Sara den Blumenduft so schnell mit 'Katzenkotze' in Verbindung bringt? Das Erlebte liegt doch so viele Jahre zurück. Es schien schon lange vergessen.
Der Madeleine-Effekt
In der Schule verteilt Saras Lehrer einen Text des französischen Schriftstellers Marcel Proust über frisch gebackene Madeleines. Sara denkt ein bisschen ans Essen und beisst sich durch den Text. Als die Hauptfigur in der Geschichte mit dem Namen Marcel Swann frisch gebackene Madeleines und Lindenblütentee riecht, nimmt die Geschichte an Fahrt auf, und Sara beginnt sich für diesen Swann zu interessieren. Ausgelöst vom Geruch erinnert sich Swann plötzlich an seine Kindheit, die er verdrängt hatte. An das Haus, den Platz, die Strassen, die Wege von damals. «Stadt und Gärten stiegen aus meiner Tasse», liest Sara. Kennt ihr das auch? Gerüche, die Erinnerungen auslösen? In der Psychologie hat dieses Phänomen einen Namen. Madeleine-Effekt oder Proust-Effekt.
Düfte und Gerüche werden in unserem Gehirn für lange Zeit gespeichert. Und zwar zusammen mit den Gefühlen und Erlebnissen, die wir beim Riechen hatten. Wenn wir später den Geruch wieder wahrnehmen, sind auch die Gefühle wieder da. Sie können sehr stark sein.
Die meisten Menschen sind wie Sara. Einige Gerüche mögen sie sehr. Gerüche, die sie an schreckliche Dinge erinnern, ertragen sie hingegen nicht. Sie bekommen dann Kopfschmerzen, Husten oder es wird ihnen schlecht. Menschen, die überhaupt keine Duftstoffe aushalten können, gibt es eher selten. Diese Menschen sind dankbar, wenn andere am Arbeitsplatz und in der Freizeit auf den übermässigen Einsatz von Parfüm oder Rasierwasser verzichten.
Unangenehme oder unerklärliche Gerüche machen uns möglichweise auch auf ein ernstzunehmendes Problem in unserer Umgebung aufmerksam. Ein solches riechbares Problem ist der Schimmelbefall in Wohnräumen.
Düfte werden in Haushaltprodukten gezielt eingesetzt. Das hat seine Gründe. Wenn ein frisch gereinigter Boden nach Zitronen duftet, empfinden wir ihn als besonders sauber. Was natürlich nicht immer stimmt. In Tat und Wahrheit sind die Düfte in den Haushaltprodukten nichts anderes als chemische Stoffe, die in die Raumluft gelangen. Die Raumluft wird dadurch schlechter. Ähnlich verhält es sich, wenn wir Duftsprays verwenden.


Ist dir in einer Wohnung schon einmal Schimmelgeruch aufgefallen? Woran denkst du, wenn du Schimmel riechst? Wahrscheinlich empfindest du den Geruch als unangenehm. Schimmelgeruch warnt dich davor, dass die Luft in der Wohnung nicht gesund ist und man handeln muss.
Unangenehme oder unerklärliche Gerüche machen uns möglichweise auch auf ein ernstzunehmendes Problem in unserer Umgebung aufmerksam. Ein solches riechbares Problem ist der Schimmelbefall in Wohnräumen.
Doch was ist Schimmel überhaupt? Vielleicht überrascht dich, dass Schimmel nicht nur aus Schimmelpilzen besteht. Schimmel ist nämlich eine Gemeinschaft aus verschiedenen Organismen: dazu gehören mehrere Arten von Schimmelpilzen und Bakterien, aber auch Milben, die kleine Spinnentierchen sind.
Schimmel in Wohnungen ist ungesund. Er belastet die Raumluft mit Sporen und verschiedenen Schimmel-Substanzen. Diese können die Atemwege, die Augen und die Haut reizen. Wir müssen husten, die Augen tränen und wir verspüren Juckreiz. Schimmel kann auch Allergien wie z.B. allergischen Schnupfen hervorrufen. Weil wir Schimmel besonders gut riechen, fühlen wir uns bei Schimmelgeruch stark belästigt. Aus all diesen Gründen gehört Schimmel nicht in Wohnungen. Eine Ausnahme sind ganz geringe Schimmelspuren. Sie beeinträchtigen die Gesundheit nicht.